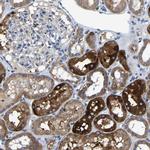
AGK Antibody in Immunohistochemistry (IHC)

Search
Invitrogen
AGK Polyclonal Antibody
{{$productOrderCtrl.translations['antibody.pdp.commerceCard.promotion.promotions']}}
{{$productOrderCtrl.translations['antibody.pdp.commerceCard.promotion.viewpromo']}}
{{$productOrderCtrl.translations['antibody.pdp.commerceCard.promotion.promocode']}}: {{promo.promoCode}} {{promo.promoTitle}} {{promo.promoDescription}}. {{$productOrderCtrl.translations['antibody.pdp.commerceCard.promotion.learnmore']}}
产品信息
PA5-54284
种属反应
宿主/亚型
分类
类型
抗原
偶联物
形式
浓度
规格
纯化类型
保存液
内含物
保存条件
运输条件
RRID
产品详细信息
Immunogen sequence: LHLSGMDVTI VKTDYEGQAK KLLELMENTD VIIVAGGDGT LQEVVTGVLR RTDEATFSKI PIGFIPLGET SSLSHTLFAE SGNKV
Highest antigen sequence identity to the following orthologs: Mouse - 96%, Rat - 96%.
靶标信息
Lipid kinase that can phosphorylate both monoacylglycerol and diacylglycerol to form lysophosphatidic acid (LPA) and phosphatidic acid (PA), respectively. Does not phosphorylate sphingosine. Overexpression increases the formation and secretion of LPA, resulting in transactivation of EGFR and activation of the downstream MAPK signaling pathway, leading to increased cell growth.
仅用于科研。不用于诊断过程。未经明确授权不得转售。
篇参考文献 (0)
生物信息学
蛋白别名: Acylglycerol kinase, mitochondrial; FLJ10842; hAGK; HsMuLK; multi-substrate lipid kinase; Multiple substrate lipid kinase; unnamed protein product
基因别名: AGK; CATC5; CTRCT38; MTDPS10; MULK
UniProt ID: (Human) Q53H12
Entrez Gene ID: (Human) 55750